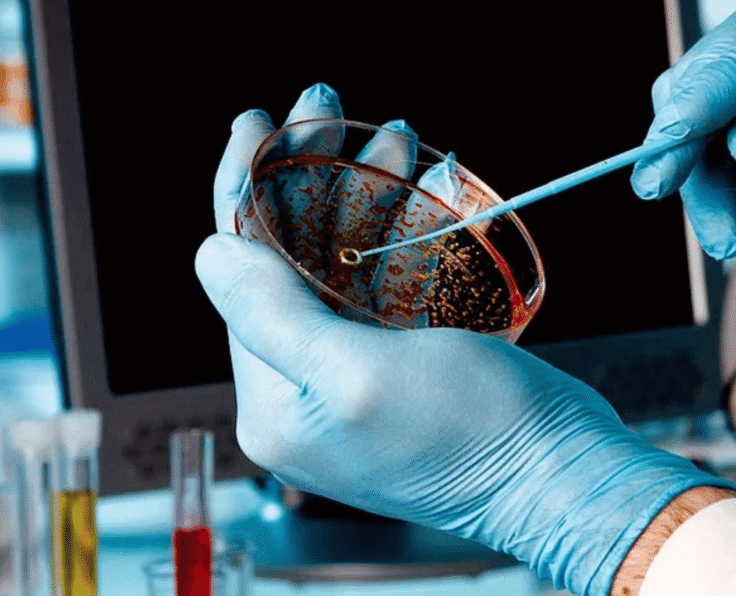
Untitled design - 2025-04-30T094143.302

Call Us when you Need Help!
Schedule Hours
Monday – Thursday
08:00 – 18:00
Friday
09:00 – 17:00
Saturday
07:30 – 20:30
Sunday
08:30 – 19:30
Our Location
Address:
info@ricgop.online
Appointments
Call us 24/7 with any emergency or to schedule an appointment and check your health.



About Us
Providing Exceptional
Healthcare for All
The Rawalpindi Institute of Cardiology (RIC) is a government hospital dedicated to providing exceptional cardiac care to patients. Equipped with state-of-the-art facilities and staffed by experienced professionals, we ensure world-class treatment for every heart. At RIC, we are committed to saving lives and improving heart health with compassion and excellence.
- Disease Prevention
- Early Diagnosis & Treatment
- Best Technology
- Improved Quality of Life
- Emergency Care & Trauma Services
- Advanced Medical
Dr. Musfireh Siddiqeh
Executive Director
Welcome to the Rawalpindi Institute of Cardiology (RIC) – a center of excellence dedicated to providing high-quality cardiac care with compassion, innovation, and integrity. At RIC, we are committed to delivering state-of-the-art cardiovascular treatment, advanced diagnostics, and lifesaving interventions. Our highly skilled team of cardiologists, surgeons, nurses, and allied healthcare professionals works tirelessly to ensure that every patient receives the best possible care.
As a premier cardiac institute, we focus on ensuring that every patient is treated with dignity, respect, and the highest medical standards, utilizing modern techniques and equipment to enhance treatment outcomes, training future healthcare professionals and contributing to advancements in cardiac medicine, raising awareness about heart diseases and promoting preventive cardiology. Our vision is to make RIC a leader in cardiovascular care, not just in Punjab but across Pakistan. We strive for continuous improvement, and your feedback is always welcome as we work to enhance our services. Thank you for trusting us with your heart health.



Services
We Provide Various Health Services
At RIC, we offer a wide range of specialized cardiac health services, from diagnostics to advanced treatments. Our goal is to ensure comprehensive care for every patient, free of cost.
Diagnostic Specialties
Emergency Care 24/7
Diagnostic Cardiology
Nutrition Services & Food Quality
Infection Control Services
Nephrology Services For Cardiac Patients
Physiotherapy and Rehabilitation Services

Why Choose Us
Dedicated to Quality Healthcare
Committed to delivering free, world-class cardiac care with compassion and excellence.
01. Experienced and Qualified Team
02. Comprehensive Services
03. State-of-the-Art Facilities
04. Convenient Locations & Hours
Years of Experience
Lorem ipsum dolor sit amet, consectetur adipiscing elit. Aenean malesuada porta sapien, in interdum urna commodo eu neque eget.
Doctors & Staff
Lorem ipsum dolor sit amet, consectetur adipiscing elit. Aenean malesuada porta sapien, in interdum urna commodo eu neque eget.
Happy Patients
Lorem ipsum dolor sit amet, consectetur adipiscing elit. Aenean malesuada porta sapien, in interdum urna commodo eu neque eget.
Hospital Rooms
Lorem ipsum dolor sit amet, consectetur adipiscing elit. Aenean malesuada porta sapien, in interdum urna commodo eu neque eget.
RIC Latest News
The Vital Role of Early Detection in Heart and Kidney Diseases
Bone Marrow Transplant: A Possible Cure for Sickle Cell Disease
What causes high blood pressure and blood fat?
An Integrated Approach to Slow Down Chronic Kidney Disease
The 3 Screenings All Men Should Have Today
Lower Back Pain with Fever: Symptoms, Causes, Diagnosis
Take the first step toward a healthier heart by consulting with the experts at RIC. Our dedicated team is here to provide you with personalized, free-of-cost cardiac care and guidance.
Patient Testimonials
Patient Stories & Experiences
Lorem ipsum dolor sit amet, consectetur adipiscing elit. Aenean libero orci, posuere sit amet neque quis.

Shakil Ahmad